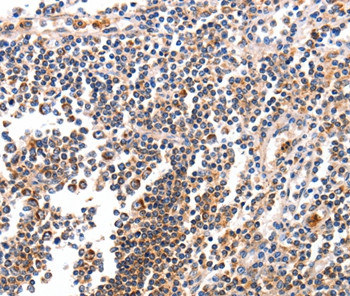
BCL2L15 Antibody in Immunohistochemistry (Paraffin) (IHC (P))

Search
Invitrogen
BCL2L15 Polyclonal Antibody
{{$productOrderCtrl.translations['antibody.pdp.commerceCard.promotion.promotions']}}
{{$productOrderCtrl.translations['antibody.pdp.commerceCard.promotion.viewpromo']}}
{{$productOrderCtrl.translations['antibody.pdp.commerceCard.promotion.promocode']}}: {{promo.promoCode}} {{promo.promoTitle}} {{promo.promoDescription}}. {{$productOrderCtrl.translations['antibody.pdp.commerceCard.promotion.learnmore']}}


Please note: We are reviewing Western blot images included in the antibody testing data in our catalog, including those provided by third parties. Unless expressly labeled or annotated as “raw-unedited”, Western blot images included in the antibody testing data in our catalog may have been edited, optimized or otherwise adjusted for presentation.
产品信息
PA5-50194
种属反应
宿主/亚型
分类
类型
抗原
偶联物
形式
浓度
规格
纯化类型
保存液
内含物
保存条件
运输条件
RRID
产品详细信息
The antibody detects endogenous levels of total BCL2L15 protein.
靶标信息
Proteins of the Bcl-2 family are critical regulators of apoptosis. Proapoptotic members, like Bax, contain three of the four Bcl-2 homology regions (BH1-3), while BH3-only proteins, like Bim, possess only the short BH3 motif. Database searches revealed Bfk, an unusual novel member of the Bcl-2 family that contains a BH2 and BH3 region but not BH1 or BH4. Bfk is thus most closely related to Bcl-G(L). It lacks a C-terminal membrane anchor and is cytosolic. Enforced expression of Bfk weakly promoted apoptosis and antagonized Bcl-2's prosurvival function. Like Bcl-G(L), Bfk did not bind to any Bcl-2 family members, even though its BH3 motif can mediate association with prosurvival proteins. Low amounts of Bfk were found in stomach, ovary, bone marrow and spleen, but its level in the mammary gland rose markedly during pregnancy, suggesting that Bfk may play a role in mammary development.
仅用于科研。不用于诊断过程。未经明确授权不得转售。
篇参考文献 (0)
生物信息学
蛋白别名: Bcl-2 family kin; Bcl-2-like protein 15; Bcl2-L-15; Bfk
基因别名: BCL2L15; C1orf178
Entrez Gene ID: (Human) 440603